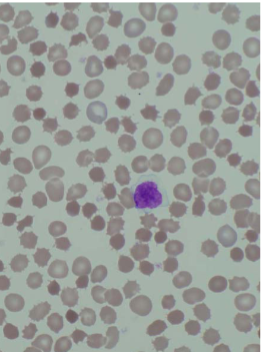
term image

1/61
Looks like no tags are added yet.
Name | Mastery | Learn | Test | Matching | Spaced | Call with Kai |
|---|
No analytics yet
Send a link to your students to track their progress
Intraluminal digestion
proteins, carbohydrates & fats are broken down in Gut Lumen before absorption
Terminal digestion
hydrolysis of carbohydrates & peptides by disaccharidases & peptidases in brush border of the small intestinal mucosa
Transepithelial transport
nutrients, fluid, & electrolytes are transported across & processed within the small intestinal epithelium
Lymphatic transport
of absorbed lipids
Malabsorption defect in chronic pancreatitis
Intraluminal digestion
Malabsorption defect in cystic fibrosis
Intraluminal digestion
Malabsorption defect in disaccharide deficiencies
Terminal digestion
Malabsorption defect in Whipple Disease
Lymphatic Transport
Malabsorption defect in Abetalipoproteinemia
Transepithelial transport
Celiac Disease (Sprue)
Gluten-sensitive Enteropathy; Nontropical Sprue
common in Europeans, less in East Asians, Africans
MHC II alleles HLA-DQ2 or DQ8 confer susceptibility
Negative genetic testing virtually excludes Celiac Disease
Chronic disease with nutrient Malabsorption caused by immune-mediated injury to small intestinal mucosa due to exposure to wheat Gliadin, an alcohol soluble, degradation resistant protein in Gluten
Celiac Disease Pathogenesis
Gluten is digested by the intestinal luminal & brush border enzymes to α-Gliadin peptide (resistant to further degradation)
α-Gliadin → epithelial cells to secrete IL-15 → recruits & activates T-cells (CD8+ Intraepithelial lymphocytes/IEL) + epithelial expression MIC-A, which is an antigenic target for T-cells → epithelial damage that enhances passage of additional α-Gliadin into lamina propria where it is Deamidated by Tissue Transglutaminase
Deamidated Gliadin is then presented by APC MHC II (DQ2 or DQ8) to CD4 Lymphs, which become activated & secrete Cytokines that do further tissue injury & induce B-cell Autoantibody production
Enterocyte injury results in villous atrophy → decreased absorptive surface

Celiac Disease
Celiac Disease Morphology
Second (Descending) part of duodenum & proximal jejunum demonstrate Dx changes best
↑ intraepithelial T-lymphocytes (CD8+/CTLs) are first sign with plasma cells, eosinophils, & mast cells in upper lamina propria
Atrophy or total loss of villi (blunted villi/flat mucosa like the colon)
↑ Crypt mitotic activity
Bx changes alone are not specific for celiac disease
Celiac Disease Clinical Features
Malabsorptive diarrhea, weight loss, fatigue
Onset at age 6-14 months with introduction of gluten → failure to thrive; weight loss, wasting, abdominal distension; chronic diarrhea
Older children often atypical
Deficiencies in Iron (refractory to oral therapy), Vit D (Osteopenia), calcium, vitamin B12, folic acid, zinc
Dermatitis Herpetiformis - vesicular skin rash with deposits of IgA
IgA anti-TG antibodies
IgA antiendomysial antibodies
Environmental Enteric Dysfunction (Tropical sprue)
poor sanitation
No accepted diagnostic criteria; No single infectious agent identified
reported to have variable immune cell infiltrates & variable villous atrophy
Oral antibiotics or nutritional supplementation do not reverse or prevent
irreversible failures of development (height, weight, cognition)
Autoimmune Enteropathy
severe persistent diarrhea & autoimmune disease that occurs most often in young children
IPEX (immune dysregulation, polyendocrinopathy, enteropathy) affects the FOXP3 gene on the X-Chromosome involved in Th4 regulatory cell function
↑ IELs & polys in small bowel but not to the extent seen in celiac disease
What drug causes intestinal morphologic features indistinguishable from celiac disease?
Olmesartan enteropathy/sprue
Olmesartan is an Angiotensin Receptor Blocker (ARB) for treatment of hypertension
Median onset: 3 years of medication (early reported case 6 months)
Clinically & histologically identical to celiac disease, EXCEPT:
has negative celiac serology (no Ab) & no response to gluten-free diet
is Reversible on upon discontinuation
Cystic Fibrosis
mutation of CFTR (Cystic Fibrosis Transmembrane Conductance Regulator) which transports Cl- ions across epithelial membranes
dehydration of luminal secretions
Thick, viscous duct contents can form obstructing intraductal concretions, creating duct dilations (cysts) & insufficiency of pancreatic enzyme secretions into the duodenal lumen
Process begins in utero
Chronic low-grade pancreatitis (autodigestion) persists→ Exocrine Pancreatic insufficiency
Pancreatic Insufficiency impairs intraluminal digestion resulting in Malabsorption
Lactase Deficiency
Lactose → Glucose & Galactose by the brush-border enzyme Lactase to enable absorption by the villus enterocytes
Without Lactase, Lactose cannot be absorbed & remains in the gut lumen → exerts an osmotic force to draw water → diarrhea
Congenital (explosive diarrhea; often fatal prior to availability of soy-based infant formula)
Acquired (↓ Lactase gene expression with age or temporarily after enteric viral or bacterial infections)
Abdominal fullness, diarrhea, flatulence (fermentation of Lactose by colonic bacteria produce Hydrogen gas)
Diarrheal stool > 50 mOsm than plasma
Decreased lactase activity

Abetalipoproteinemia
Duodenal Enterocytes with a clear cytoplasm (due to lipid accumulation)
Abetalipoproteinemia
Acanthocytosis of RBCs
Abetalipoproteinemia
Autosomal Recessive
Presents in infancy as failure to thrive, Diarrhea, Steatorrhea
Caused by inability to transfer lipids to Apolipoprotein B to make Lipoproteins
Defect in Microsomal TG transfer protein (MTP) → lipids stay inside enterocytes
Plasma is devoid of all Lipoprotein particles containing Apolipoprotein B
Blind loop/Small Bowel Bacterial Overgrowth (SBBO) syndrome
chronic watery diarrhea and/or steatorrhea, & with anemia due to B12 deficiency
Weight loss & abdominal pain
Bacterial overgrowth in the small bowel in areas of stagnation or slowing of peristaltic stream stricture, stenosis, fistulas, diverticula, complication of abdominal surgery that create blind loops (Gastrojejunostomy; “bowel-shortening” surgery for obesity,), impaired intestinal motility (Diabetic Autonomic Neuropathy), Systemic Sclerosis, loss of gastric acidity, radiation to the abdomen, Crohn disease, hypogammaglobulinemia
Chronic diarrhea & malabsorption occur due to bacterial overgrowth & recurrent GI infections
Cholera
Vibrio Cholera, a comma-shaped Gram-Negative bacterium
Spread via human Fecal contamination of drinking water
Causes a Secretory watery diarrhea via Cholera toxin by stimulation of cAMP which opens CFTR to secrete Cl- into the intestinal lumen
Most cases asymptomatic or mild diarrhea
Severe symptomatic disease:
rice water stools with flecks of mucus
Diarrhea leads to dehydration → relative polycythemia, anuria, electrolyte loss with muscle cramping; hypotension; hypovolemic shock, & w/o therapy, often death
Fluid replacement
Antibiotics for severely ill
Prophylactic Vaccine available
Campylobacter jejuni
comma-shaped, flagellated, gram-negative
traveler's diarrhea & food poisoning
Infections are most often associated with ingestion of improperly cooked chicken, but outbreaks can also be caused by unpasteurized milk or contaminated water
Morphology: colonic neutrophilic cryptitis or crypt abscesses
Watery diarrhea, either acute or following an influenza-like prodrome
dysentery (bloody diarrhea)
Infection can result in Reactive Arthritis, primarily in HLA-B27 +
Erythema Nodosum & Guillain-Barré syndrome via molecular mimicry to nervous system gangliosides
Shigellosis
gram-negative facultative anaerobe
Bloody diarrhea (Dysentery)
Humans are only reservoir; highly transmissible by the fecal-oral route or via contaminated water, food
Resistant to gastric acid → invade M cells over Peyer Patches first → escape into lamina propria & cause inflammation & invade epithelial cells from below causing aphthous ulcers
Shigella Dysenteriae serotype 1 also releases Shiga toxin (Stx/Verotoxin) → inhibits eukaryotic protein synthesis → cell damage/death including systemic endothelial cell injury → HUS (Hemolytic-Uremic syndrome)
Self-limited disease characterized by 7-10 days of Diarrhea, fever, & abdominal pain
Watery diarrhea → dysenteric phase; constitutional symptoms can persist for as long as 1 month
Antibiotics shorten clinical course & duration of bacterial shedding in stools
Reactive Arthritis that preferentially affects HLA-B27–positive men 20-40 years old
Toxic megacolon & intestinal obstruction are rare
Salmonella
gram-negative bacilli
Salmonella typhi (cause of Typhoid Fever) & nontyphoid Salmonella Enteritidis
Infection is most common in young children & older adults, with peak incidence in the summer & fall
Salmonella is transmitted via contaminated food, particularly raw or undercooked meat, poultry, eggs, & milk
Vaccines are available for both humans & farm animals
Loose stools to cholera-like profuse diarrhea to dysentery
Fever often resolves within 2 days, but diarrhea can persist for a week, & organisms can be shed in the stool for several weeks
Antibiotic therapy is not recommended as it can prolong the carrier state or cause relapse & does not shorten the duration of diarrhea
Antibiotics are indicated for Salmonella typhi
Reactive arthritis, meningitis, & even death, particularly in patients with malignancies, immunosuppression, alcoholism, cardiovascular dysfunction, sickle cell disease, or hemolytic anemia
Typhoid Fever (Enteric Fever)
Salmonella typhi & S. paratyphi
Humans are only reservoir
person to person or via food or contaminated water
Chronic carrier states are associated with Gallstone colonization as biofilms
S. typhi disseminates via lymphatic & blood vessels causing systemic reactive hyperplasia of lymphoid tissues
S. typhi is resistant to gastric acid & initially invade via small intestinal M cells
Terminal Ileum Mucosal Lymphoid Hyperplasia: Enlargement of mucosal Peyer’s patches (plateau-like, well delineated elevations)
Oval mucosal ulcerations oriented along the long axis of the ileum, overlying hyperplastic Peyer’s patches are a risk of perforation
Mesenteric lymphadenopathy
Splenomegaly: soft; homogenous due to diffuse infiltrates of macrophages
Typhoid nodules: macrophage aggregates surround necrosis in liver, bone marrow, lymph nodes
Symptoms/Stages of Typhoid Fever
Abd. pain, anorexia, nausea, vomiting, bloody diarrhea
Sepsis; bacteremia: fever, chills, flu-like
Blood cultures usually positive
Relative Bradycardia; Neutropenia
Abdominal pain from hepatosplenomegaly
Rose spots: Maculopapular erythema anterior trunk
S. typhi may be cultured from biopsy
Ulceration Peyer’s patches, GI bleeding/risk of perforation & shock
Systemic complications include inflammation of CNS, heart, lungs
Gallstone biofilm colonization → resistant to Antibiotics → chronic carrier state
Antibiotics halt progression
Yersinia Enterocolitica + Pseudotuberculosis
Ingestion of pork, raw milk, contaminated water & tend to cluster in the winter
Preferentially involves the Ileocecum
Peyer’s patch lymphoid hyperplasia/ apthous ulcers
Abdominal pain, N & V, & abdominal tenderness, Fever & diarrhea
Pharyngitis, arthralgia, & erythema nodosum
Peyer patch invasion with Mesenteric Adenitis can mimic acute Appendicitis (Pseudoappendicitis)
In teenagers & young adults can also cause Appendicitis (Granulomatous)
Enteritis & colitis predominate in younger children
Reactive arthritis with urethritis & conjunctivitis (Reiter Syndrome), myocarditis, erythema nodosum, & kidney disease
Antibiotics for severe cases
Escherichia Coli
gram-negative bacilli
fecal-oral route (contaminated food or water), except for EHEC which has a natural reservoir in cows
Enterotoxigenic E. coli (ETEC)
Principal cause of traveler's diarrhea
Noninvasive but secrete heat-labile (LT) & heat-stable (ST) toxins → watery diarrhea
minimal histologic changes (Non-inflammatory)
Dehydration & shock
Enteropathogenic E. coli (EPEC)
endemic diarrhea + diarrheal outbreaks, particularly in children less than 2 years of age
bacteria attach tightly to small enterocyte apical membranes & cause local loss of microvilli & cause watery diarrhea
Enterohemorrhagic E. coli (EHEC)/Shiga-toxin producing (STEC)
E. coli O157:H7 or non-O157:H7 serotypes
Inadequately cooked ground beef (natural reservoir in cows) or contaminated milk & vegetables
Bloody diarrhea & Shiga-like toxins → systemic endothelial injury → Hemolytic-Uremic Syndrome
Antibiotics are not recommended (bacterial killing releases the Shiga-like toxins & ↑ risk of HUS, especially in children)
Enteroinvasive E. coli (EIEC)
Bacteriologically like Shigella, but do NOT produce toxins
Usually watery diarrhea
Common among young children in third world
Enteroaggregative E. coli (EAEC)
“stacked brick” morphology when bound to epithelial cells
Causes non-bloody diarrhea in children & adults worldwide, including traveler's diarrhea
Pseudomembranous Colitis
caused by Clostridioides difficile
Diarrhea due to disruption of normal colonic microbiota by antibiotics that allows overgrowth of toxigenic strains of C. difficile
spore-forming, Gram-positive anaerobic bacillus, exotoxins → mucosal injury & inflammation (toxin A & toxin B)
diarrhea in hospitalized patients
Risk factors for toxigenic C. difficile-associated colitis include antibiotic Rx, advanced age, hospitalization & immunosuppression
fever, leukocytosis, abdominal pain, cramps, watery diarrhea & dehydration
Toxic megacolon, marked dilatation of the colon, resulting from marked injury to the colonic wall
C Diff Lab Testing
PCR assays for genes encoding toxins
Culture not useful
Enzyme immunoassay detects both Toxin A & Toxin B separately (both A & B must be assayed)
Fecal leukocytes & occult blood may be present
Patients with formed stools should not be tested for C. difficile!
Colonized patients may be test positive for toxigenic C. Diff. & have no symptoms!
Dx requires both detection of toxigenic C. difficile + clinical symptoms or characteristic pseudomembranous colitis by biopsy histopathology

C diff
“Volcanic eruption” or “Mushroom clouds” (mucopurulent exudate extends from abscessed crypts into the lumen)

C diff
“Volcanic eruption” or “Mushroom clouds” (mucopurulent exudate extends from abscessed crypts into the lumen)

C diff
Surface epithelium denuded; lamina propria infiltrated by neutrophils
Pseudomembranes = plaque-like adhesion of purulent/necrotic debris to mucosa

C diff
Pseudomembrane

C diff
Pseudomembrane

C diff

C diff
Crypt abscess with mucosal explosive or volcano lesions
Whipple Disease
Caused by infection & proliferation gram-positive Actinobacterium, Tropheryma whipplei
Bacteria-laden macrophages accumulate within the small intestinal lamina propria & mesenteric lymph nodes, causing Lymphatic Obstruction
Malabsorptive diarrhea due to impaired lymph drainage
Malabsorptive diarrhea, weight loss, & arthralgia
Extraintestinal symptoms may precede malabsorption: arthritis, fever, lymphadenopathy, & neurologic, cardiac, or pulmonary disease
Bacteria-laden macrophages can accumulate
Endoscopic small bowel
Periodic acid-Schiff (PAS) + AFB - Macrophages in lamina propria
Antibiotics long term (1-2 years)

Whipple Disease
effacement of lamina propria by a sheet of distended macrophages

Whipple Disease
effacement of lamina propria by a sheet of distended macrophages
Intestinal Tuberculosis (Mycobacterium Tuberculosis)
immigrants, immunosuppressed
GI tract may be involved without active pulmonary disease
Ileo-cecal region of intestine is most commonly affected
mucosal destruction causes malabsorption; strictures & fistulae
Biopsy also may contain granulomas
Mycobacterium via AFB stain, PCR or culture of biopsy tissue

mycobacteria are also positive with acid-fast stain

Norovirus
Humans are only reservoir
Transmission: contaminated food or water or via person-to-person fecal-oral transmission, & includes airborne droplets & fomites
vomiting; cramping abdominal pain; watery diarrhea; headache, chills, myalgias
Small bowel ↑ intraepithelial & lamina propria lymphocytes & crypt hypertrophy
Can cause chronic diarrhea in the immunocompromised
Many people are “Non-secretors” & are resistant to infection because they lack the carbohydrate groups that serve as ligands for viral infection
Rotavirus
Rotavirus infects & destroys small bowel mature enterocytes with loss of absorptive function
Usually asymptomatic in adults, but may cause diarrhea
Rotavirus vaccine
Adenovirus
pediatric diarrhea
also affects immunocompromised patients
diarrhea, vomiting, & abdominal pain
Fever may also be present
Strongyloides
entire life cycle inside patient (Autoinfection)
infection persists for life & in immunosuppression can lead to overwhelming infection
Entamoeba histolytica (Amebiasis)
Fecal-oral spread
abd pain, bloody diarrhea, weight loss
Cecum, ascending colon most involved
flask-shaped mucosal ulcers which can coalesce
Ameba resemble macrophages; ingest RBCs
Liver abscess with dysentery
Rx: Metronidazole
Giardia intestinalis (lamblia)
Water-borne by fecal contamination; not killed by chlorine
Flagellated protozoan in two forms
Cyst form enables fecal-oral infection
Trophozoites: Multiply in duodenal lumen; flagella; binucleate; adheres to brush border of villous enterocytes but do not invade
Parasite proteins damage brush border
enzymes decreased, including lactase
microvillous damage; apoptosis may lead to blunted villous processes
Clinical forms: subclinical, acute diarrhea, chronic diarrhea, constipation
Malabsorptive diarrhea (steatorrhea; weight loss)
Severe in malnourished individuals or in IgA deficiency or agammaglobulinemia (plasma cells absent in lamina propria)
Acquired lactase deficiency
Recurrence/relapse common (continuously modifies major surface antigen)
Treatment: Metronidazole

Giardia

Giardia

Giardia

Giardia
Cryptosporidium
Massive, persistent watery diarrhea
Acute self-limited disease in immunologically normal hosts
may cause traveler’s diarrhea
oocysts resistant to chlorine
Species include C parvum & C. hominis
Ingested oocysts activated by by gastric acid; attach to enterocyte brush border forms vacuole
Pathogenesis of diarrhea: sodium malabsorption; chloride secretion; tight junction permeability
infectious enterocolitis GI Panel
Multiplex PCR stool testing that can be done in an hour